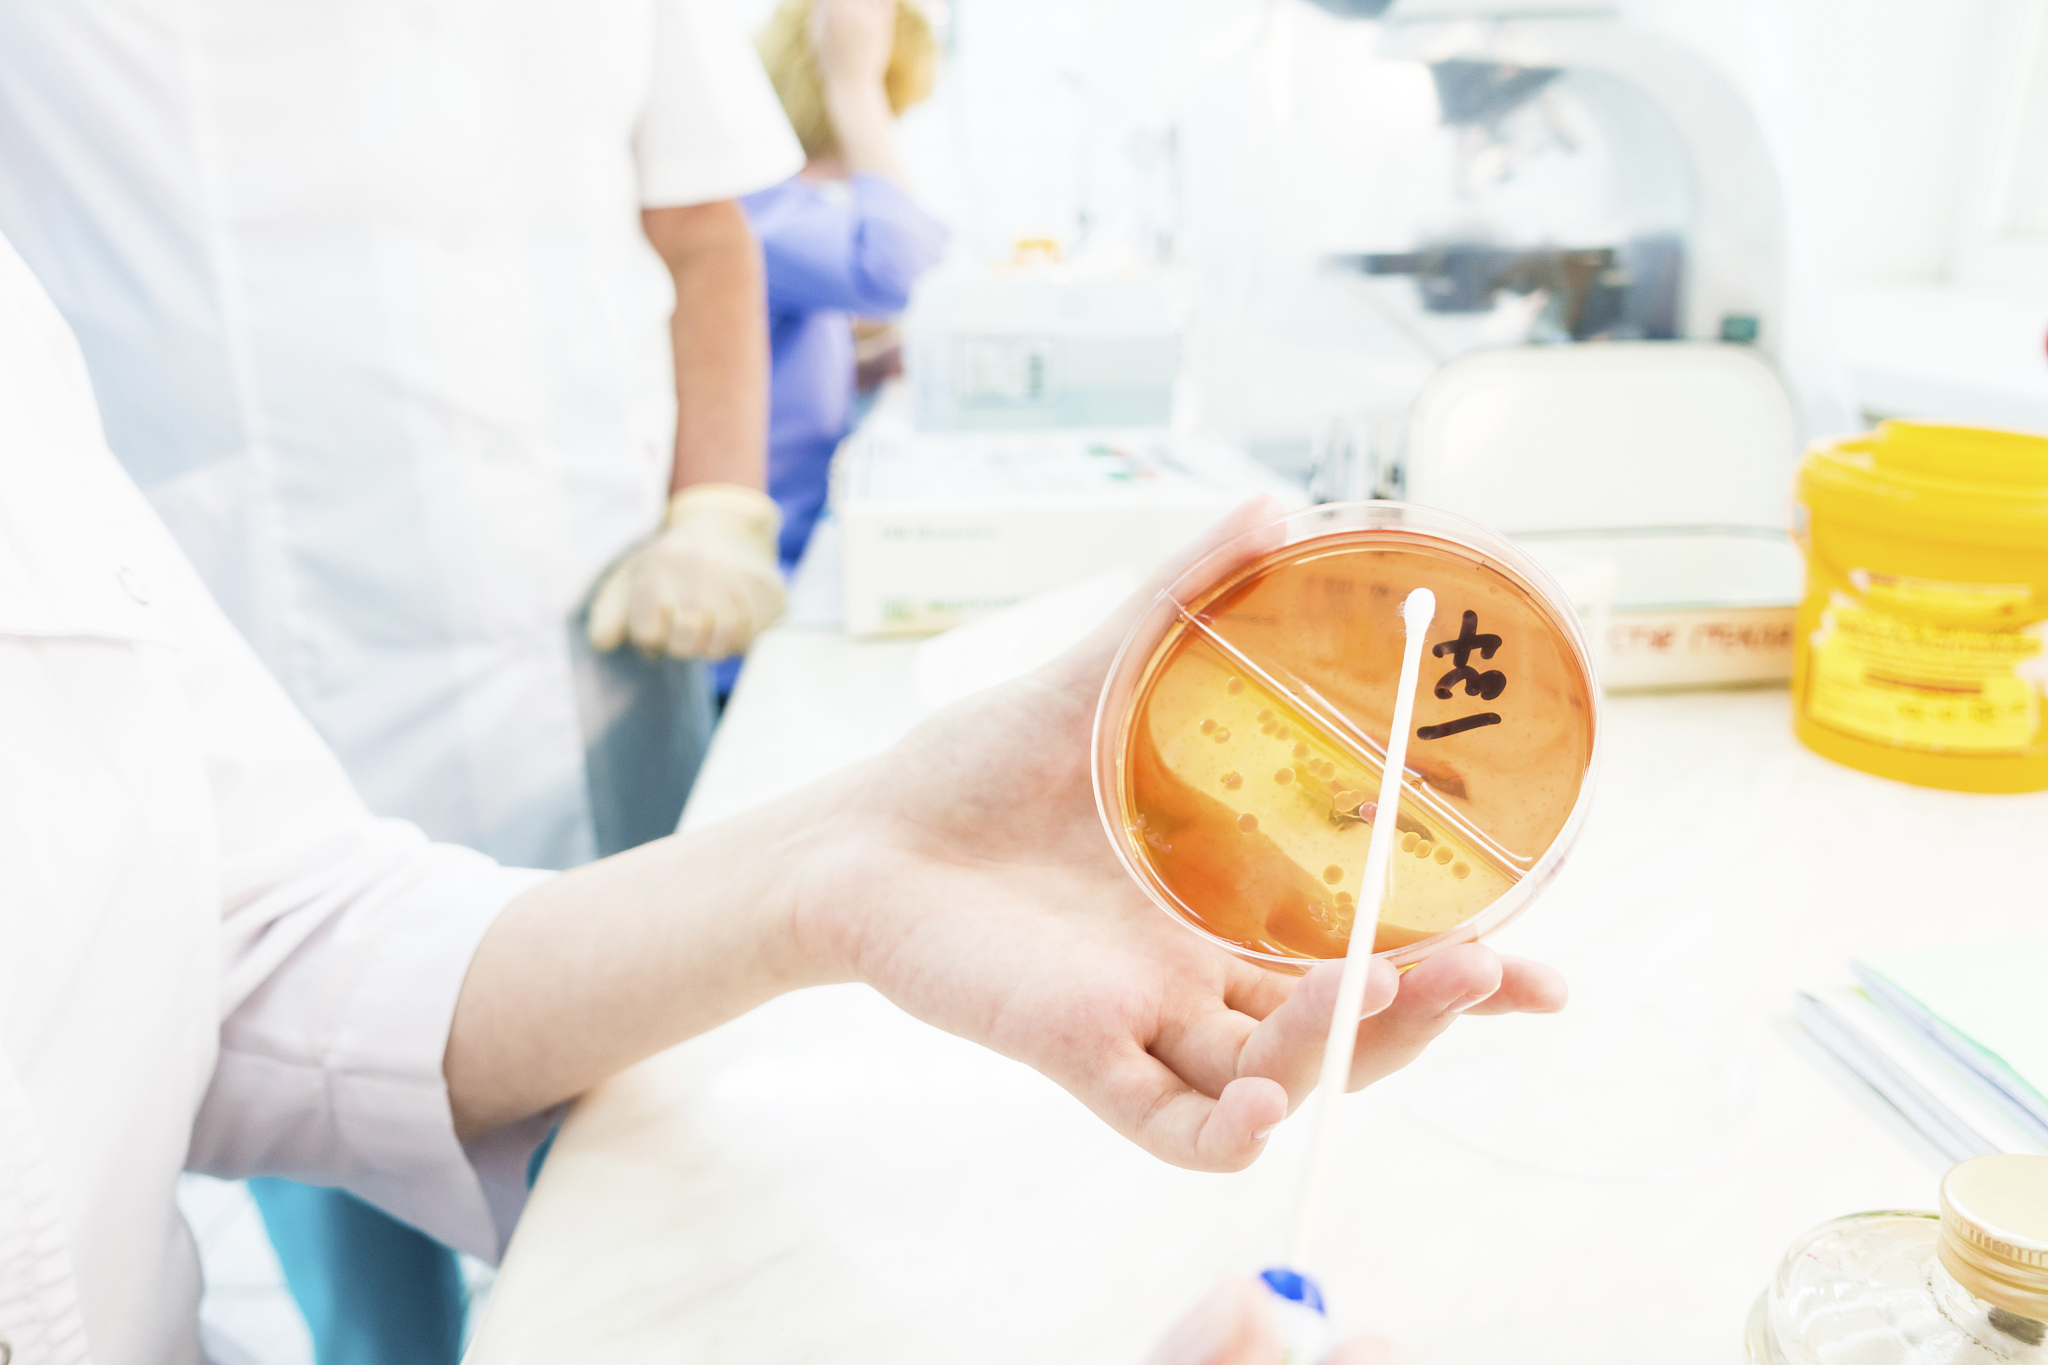
直径10cm的培养皿铺满细胞时细胞数大概是多少假定细胞全覆盖

直径10cm的培养皿铺满细胞时细胞数大概是多少假定细胞全覆盖
首先,我们需要计算培养皿的面积。培养皿的直径为10cm,那么半径为5cm。培养皿的面积可以用圆的面积公式计算:
面积 = π * 半径^2
面积 = 3.14 * 5^2 = 3.14 * 25 ≈ 78.5 cm²
接下来,我们需要计算细胞的平均面积。假设细胞是圆形,那么细胞的面积可以用圆的面积公式计算:
面积 = π * 半径^2
假设细胞的半径为r,那么细胞的面积可以表示为:
面积 = π * r^2
由于细胞全覆盖培养皿,那么细胞的面积应该等于培养皿的面积:
π * r^2 = 78.5
解方程,可以得到细胞的半径r:
r^2 = 78.5 / π r ≈ √(78.5 / π) r ≈ √(25) r ≈ 5
细胞的半径约为5cm。
最后,我们可以计算细胞的数量。培养皿的面积除以细胞的面积,即可得到细胞的数量:
细胞数量 = 培养皿面积 / 细胞面积 = 78.5 / (π * 5^2) ≈ 78.5 / (3.14 * 25) ≈ 78.5 / 78.5 ≈ 1
所以,直径为10cm的培养皿铺满细胞时,细胞数大约为1个。
原文地址: https://www.cveoy.top/t/topic/iCeF 著作权归作者所有。请勿转载和采集!